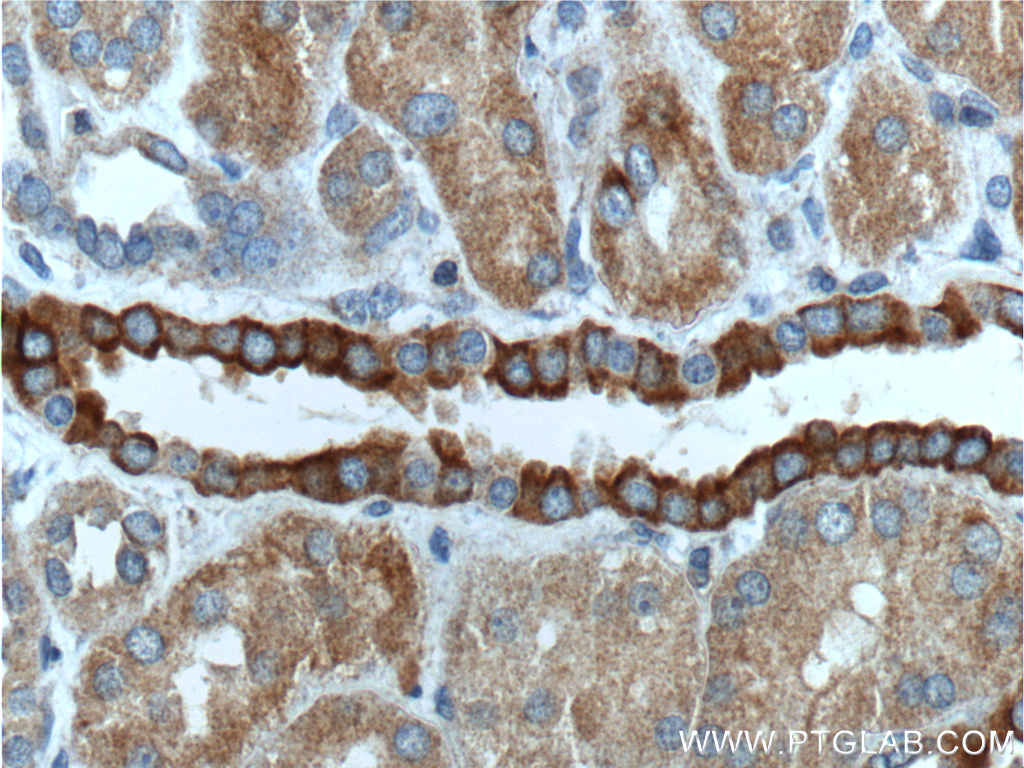

验证数据展示
经过测试的应用
| Positive WB detected in | A2780 cells, Caco-2 cells, U2OS cells, COLO 320 cells, HeLa cells, K-562 cells |
| Positive IP detected in | HeLa cells |
| Positive IHC detected in | human lung cancer tissue, human breast cancer tissue, human kidney tissue Note: suggested antigen retrieval with TE buffer pH 9.0; (*) Alternatively, antigen retrieval may be performed with citrate buffer pH 6.0 |
| Positive IF/ICC detected in | U2OS cells |
推荐稀释比
| 应用 | 推荐稀释比 |
|---|---|
| Western Blot (WB) | WB : 1:500-1:2000 |
| Immunoprecipitation (IP) | IP : 0.5-4.0 ug for 1.0-3.0 mg of total protein lysate |
| Immunohistochemistry (IHC) | IHC : 1:50-1:500 |
| Immunofluorescence (IF)/ICC | IF/ICC : 1:200-1:800 |
| It is recommended that this reagent should be titrated in each testing system to obtain optimal results. | |
| Sample-dependent, Check data in validation data gallery. | |
产品信息
55114-1-AP targets NOTCH3 in WB, IHC, IF/ICC, IP, ELISA applications and shows reactivity with human, mouse samples.
| 经测试应用 | WB, IHC, IF/ICC, IP, ELISA Application Description |
| 文献引用应用 | WB, IHC, IF, IP |
| 经测试反应性 | human, mouse |
| 文献引用反应性 | human, mouse, rat, goat |
| 免疫原 |
Peptide 种属同源性预测 |
| 宿主/亚型 | Rabbit / IgG |
| 抗体类别 | Polyclonal |
| 产品类型 | Antibody |
| 全称 | Notch homolog 3 (Drosophila) |
| 别名 | CADASIL, CASIL, Notch 3, Notch homolog 3 (Drosophila) |
| 计算分子量 | 244 kDa |
| 观测分子量 | 250-260 kDa, 100 kDa |
| GenBank蛋白编号 | NM_000435 |
| 基因名称 | NOTCH3 |
| Gene ID (NCBI) | 4854 |
| RRID | AB_10858393 |
| 偶联类型 | Unconjugated |
| 形式 | Liquid |
| 纯化方式 | Antigen affinity purification |
| UNIPROT ID | Q9UM47 |
| 储存缓冲液 | PBS with 0.02% sodium azide and 50% glycerol, pH 7.3. |
| 储存条件 | Store at -20°C. Stable for one year after shipment. Aliquoting is unnecessary for -20oC storage. |
背景介绍
NOTCH3 belongs to the NOTCH family. It functions as a receptor for membrane-bound ligands Jagged1, Jagged2 and Delta1 to regulate cell-fate determination. Upon ligand activation through the released notch intracellular domain (NICD) it forms a transcriptional activator complex with RBP-J kappa and activates genes of the enhancer of split locus. NOTCH3 affects the implementation of differentiation, proliferation and apoptotic programs. Defects in NOTCH3 are the cause of cerebral autosomal dominant arteriopathy with subcortical infarcts and leukoencephalopathy (CADASIL). The antibody is specific to NOTCH3. Notch3 is a single-pass type I membrane protein exposed at the cell surface as a heterodimer of 2321 amino acids. It is synthesized as a precursor with a molecular weight of ~280 kDa (Notch3 full-length), which is cleaved (S1 cleavage) into a 210 kDa extracellular fragment and a 97 kDa intracellular fragment (PMID: 21702048).
实验方案
| Product Specific Protocols | |
|---|---|
| IF protocol for NOTCH3 antibody 55114-1-AP | Download protocol |
| IHC protocol for NOTCH3 antibody 55114-1-AP | Download protocol |
| IP protocol for NOTCH3 antibody 55114-1-AP | Download protocol |
| WB protocol for NOTCH3 antibody 55114-1-AP | Download protocol |
| Standard Protocols | |
|---|---|
| Click here to view our Standard Protocols |
发表文章
| Species | Application | Title |
|---|---|---|
Cell Metab Mitochondrial Dynamics Is Critical for the Full Pluripotency and Embryonic Developmental Potential of Pluripotent Stem Cells. | ||
Sci Transl Med JAGGED-NOTCH3 signaling in vascular remodeling in pulmonary arterial hypertension. | ||
Mol Ther METTL3-mediated m6A modification of TIMP2 mRNA promotes podocyte injury in diabetic nephropathy. | ||
Cancer Res Manic fringe promotes a claudin-low breast cancer phenotype through notch-mediated PIK3CG induction. | ||
Oncogene Notch3 promotes prostate cancer-induced bone lesion development via MMP-3.
|